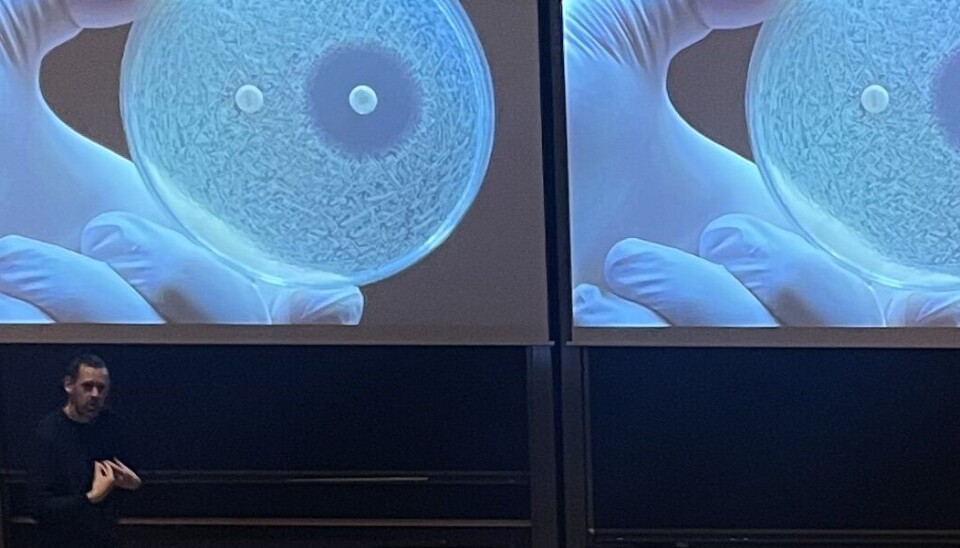
Fra foredrag: Jørn-Åge Longva forteller om antibiotikaresistens for Senioruniversitetet.

Unge vet for lite om antibiotikaresistens:
– Kan bli vanskeligere å behandle kjønnssykdommer
Antibiotikaresistens øker – og det kan få alvorlige konsekvenser, særlig for unge. Kjønnssykdommer som gonoré krever antibiotikabehandling, men bakteriene blir stadig mer motstandsdyktige.
Det ble nylig arrangert et foredrag om antibiotikaresistens ved Høgskulen i Volda for pensjonistene i Ørsta og Volda. Men hva vet egentlig de unge om risikoen?
– Problemet er at vi får bakterier som er resistente. Du kan ikke lenger bare ta en tablett. I økende grad må man ha sprøyte, og i noen land er det nesten ikke mulig å behandle gonoré lenger.
Kjønnssykdommer rammer flest unge
Antibiotikaresistens er et globalt problem, og det påvirker behandling av seksuelt overførbare infeksjoner (SOI-er). Ifølge Forskning.no ble over 3100 nordmenn smittet av gonoré i 2024, og de fleste av dem er unge voksne.
– Man skal bruke antibiotika i så kort tid og så begrenset omfang som mulig. Hver kur påvirker de gode bakteriene vi har i kroppen, som i tarmen, og det øker sjansen for utvikling av motstandsdyktige bakterier, sier Longva.

Han understreker at det ikke er mennesker som blir resistente – det er bakteriene. Og det gjør behandlingen langt vanskeligere.
– Vi får færre behandlingsalternativer, og i verste fall kan man bli sykere eller få komplikasjoner fra det som egentlig begynte som en bagatell.
Ikke bare et problem for eldre
Selv om det var eldre i salen under foredraget, mener Longva at unge burde være en minst like viktig målgruppe for informasjon om resistens.
– De unge har hele livet foran seg. Mange av dem skal kanskje ha barn en dag, og da er det viktig å ha et bevisst forhold til infeksjoner og antibiotikabruk. Det gjelder alt fra urinveisinfeksjoner til sykdom hos små barn.
Han peker også på at kvinner bruker mer antibiotika gjennom livet, blant annet på grunn av urinveisinfeksjoner og kjønnssykdommer. Samtidig er det ofte de som oppsøker lege raskere enn menn.
Forebygging er nøkkelen
Forebygging og beskyttelse er derfor mer aktuelt enn noen gang. Bruk av kondom og regelmessig testing er avgjørende for å unngå kjønnssykdommer – og i neste omgang, å måtte bruke antibiotika.
– God håndvask, smittevern og det å ta minst mulig antibiotika er helt grunnleggende.
Når det gjelder kjønnssykdommer, er budskapet enkelt:
– Det aller viktigste er å beskytte seg i utgangspunktet. Da slipper man problemet, avslutter Jørn-Åge Longva.
Han avslutter med å understreke at nye behandlingsmetoder ligger langt frem i tid. Det finnes håp i forskning på genterapi, immunterapi og vaksiner – men inntil videre er det verktøyene vi allerede har som må brukes med omhu.